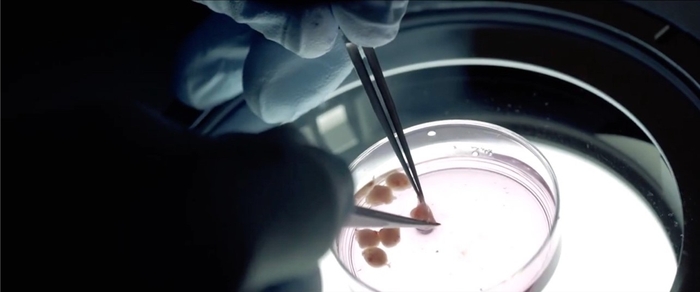
動物の胚から細胞組織を採取している様子

世界初!培養肉に用いる細胞を効率的に増やす食品添加物を発見 低コストで環境負荷が少ない培養肉の生産技術確立に期待

近畿大学大学院農学研究科(奈良県奈良市)博士前期課程2年 片山ともか、近畿大学農学部(奈良県奈良市)生物機能科学科講師 岡村 大治らの研究グループは、徳島大学先端酵素学研究所(徳島県徳島市)との共同研究により、培養肉※1(代替肉)の製造に用いる筋芽細胞※2 を、低濃度の血清培地※3 でも効率的に増やすことができる食品添加物を発見しました。
現在、世界各国で、細胞培養によって作り出される培養肉の研究・開発が本格化していますが、培養にはウシ胎児血清※4 や成長因子と呼ばれるタンパク質が必要であり、高コストの原因となっています。本研究成果により、それらを大幅に削減できる可能性があり、将来的に低コストで環境負荷が少ない、安全な培養肉の生産技術の確立につながることが期待されます。
本件に関する論文が、令和5年(2023年)5月12日(金)に、国際的科学誌"Frontiers in Cell and Developmental Biology"に掲載されました。
【本件のポイント】
●低濃度の血清を添加した培養においても、筋芽細胞の増殖を促進する食品添加物メチル-β-シクロデキストリン※5 (以下、MβCD)を発見
●MβCDが筋芽細胞の分化を抑制し、細胞の増殖を促すメカニズムを解明
●低コストで環境負荷が少ない、培養肉の生産技術確立への貢献に期待
【本件の背景】
現在の畜産は、SDGsを達成する上で、水や穀物の過剰消費、肥育スペースや飼料生産のための森林伐採、家畜の排泄物による水質汚染・地球温暖化への悪影響などが大きな課題となっています。今後、世界的に人口増加していく状況も考慮すると、持続可能な食肉生産システムの確立が急務となっています。
家畜の骨格筋細胞※6 を培養・組織化した「培養肉」は、新たな食肉生産システムとして期待されていますが、培養肉の元となる細胞を効率よく増殖させるためには、ウシ胎児血清や成長因子と呼ばれる組み換えタンパク質を培養液に補充する必要があり、コストがかかります。また、そもそも培養肉生産の目的は、家畜への依存を減らし、環境破壊を軽減することにあるにも関わらず、生産にウシ胎児血清を使用することは、目的と矛盾しているという問題もあります。
現状、成長因子を加え血清を用いない培地が開発されていますが、今後、培養肉を低コストで生産するためには、成長因子も添加せずに増殖を促進できる培養技術が必要となります。
【本件の内容】
将来、培養肉を大規模に生産するためには、コストや倫理的・環境的な問題を回避するためにも、筋繊維※7 の元となる筋芽細胞を効率よく増殖させる必要があります。しかし、マウスやニワトリの骨格筋に含まれる筋芽細胞は、血清濃度の高い培地中では活発に増殖しますが、血清濃度の低い培地(低血清培地)に交換すると、増殖を停止し筋管細胞へと分化してしまいます。つまり、筋肉の分化過程で唯一増殖性をもつ筋芽細胞は、低血清もしくは無血清培地中においては分化が進行してしまい、その増殖性を失ってしまうという特性があります。
そこで研究グループは、低血清培地で筋芽細胞の分化を抑制する物質として、食品添加物である、デンプン由来の環状オリゴ糖MβCDに注目しました。そして、検証の結果、MβCDは低血清培地条件下においてマウス骨格筋の筋芽細胞やニワトリ胚初代培養※8 の筋芽細胞の分化を強力に抑制することと、その分化抑制効果により筋芽細胞の増殖性維持に寄与することを明らかにしました。
将来、培養肉が社会に実装され普及するためには、無血清培地をベースとした低コストで環境負荷のない生産技術を確立させることが極めて重要であり、本研究成果はその第一歩となると期待されます。
【論文掲載】
掲載誌 :Frontiers in Cell and Developmental Biology
(フロンティアズ イン セル アンド デベロップメンタル バイオロジー、インパクトファクター:6.081@2021)
論文名 :The ensured proliferative capacity of myoblast in serum-reduced conditions with Methyl-β-cyclodextrin
(メチル-β-シクロデキストリンによる低血清培地での筋芽細胞の増殖促進効果)
著者 :片山 ともか1、千木 雄太3、岡村 大治1,2* *責任著者
所属 :1 近畿大学大学院農学研究科、2 近畿大学農学部、3 徳島大学先端酵素学研究所
DOI :10.3389/fcell.2023.1193634
掲載URL:https://doi.org/10.3389/fcell.2023.1193634
【研究の詳細】
研究グループは、血清が少なく成長因子がない培地でも筋芽細胞を増殖させる技術開発を目的として、マウス骨格筋・筋芽細胞株C2C12細胞やニワトリ胚由来の筋芽細胞を材料とし、MβCDの低血清培地条件下での分化抑制と増殖促進効果について、詳細な解析を行いました。MβCDは食品添加物の一つでありながら、細胞膜のコレステロール※9 除去効果が非常に大きい物質として知られています。低血清条件下で培養するC2C12細胞にMβCDを添加すると、筋管細胞が分化した指標(マーカー)のタンパク質であるMHCが陽性となる細胞数が著しく減少し、さらにはMHC陽性細胞においてもその核数が有意に減少しました。RNAシーケンス解析により、MβCDを投与した細胞ではコントロールと比較して、筋管細胞への分化が効果的に抑制されていただけでなく、細胞分裂関連遺伝子の発現レベルが高い、つまり活発な増殖が維持されていることが確認されました。そこで、低血清条件下での細胞増殖能力に対するMβCDの効果を調べたところ、細胞増殖の促進効果と共に、細胞増殖でみられる有糸分裂のマーカーであるリン酸化ヒストンH3陽性細胞が有意に増加していることが明らかになりました。
さらに、ニワトリ筋芽細胞の初代培養を用いて、MβCDの分化抑制と増殖促進効果を評価しました。ニワトリ大腿筋・筋芽細胞を10日齢のニワトリ胚から採取し、低血清条件下で筋分化と細胞増殖に対するMβCDの効果を評価したところ、MβCDは動物種を越えて、筋芽細胞の分化抑制と増殖促進効果を発揮することがわかりました。
筋芽細胞の分化は、細胞がアポトーシス※10 による細胞死を起こし、そのシグナルが隣接する細胞に伝達されることで筋芽細胞同士が融合して起こると報告されています。研究グループは、このアポトーシスによる細胞死がコレステロール依存的に生じることを世界で初めて明らかにしました。このことから、MβCDの添加による筋芽細胞の分化抑制は、MβCDがコレステロール依存的な筋芽細胞のアポトーシスによる細胞死を効果的にブロックすることで、筋芽細胞の分化進行(細胞融合)を抑制していると示唆されました。
無血清培地を用いた安全で低コストな骨格筋細胞の増殖技術の確立は、培養肉の商業的・社会的な生産に不可欠と考えられます。本研究成果は、食品添加物であるMβCDの使用により、低血清培地中にもかかわらず、筋細胞の分化を抑制し増殖能を維持できることを示し、将来の培養肉生産の無血清化の重要な一歩となります。安全性の高い物質を用いて筋芽細胞の分化抑制を実現することが、ウシ胎児血清や成長因子に依存しない筋芽細胞の増殖技術実現への有効なアプローチとなり得ると期待されます。

【研究者のコメント】
岡村 大治(おかむら だいじ)
所属 :近畿大学農学部生物機能科学科
近畿大学大学院農学研究科
職位 :講師
学位 :博士(医学)
コメント:家畜による食肉生産には膨大なリソース(飼料、水、土地等)を必要とし、限られたリソースしかもたない我が国において(土地や、輸入に依存する大豆やとうもろこしなどの飼料)、少ないリソースで家畜に代わるタンパク源を生産できる技術の確保は、食料安全保障環境の改善にも大きく貢献できると考えられます。「筋芽細胞の分化を抑制することで、低血清培地でも増殖性を維持できる」という研究コンセプトは過去に例がなく、今回その点に気づいた第一著者の片山さんの貢献はとても大きかったです。
【用語解説】
※1 培養肉:動物の骨格筋細胞を培養した食肉の代替品。細胞培養の培地にウシ胎児血清が用いられることが一般的であったが、大量調達が難しい点やコスト面や動物倫理の問題などの理由から、非動物性成分の成長因子の開発が進められている。しかし成長因子の生産コストもまた高額であることが課題となっている。現在、世界中で数多くのスタートアップ企業が培養肉開発に参入しており、国家レベルでの開発支援対象となっている。
※2 筋芽細胞:筋線維の元となる細胞。試験管内において、筋芽細胞は高血清培地条件下で細胞分裂を繰り返し、その後、低血清条件に変わることで増殖を停止し、筋管細胞へと分化する。
※3 血清培地:動物性血清を含む、動物細胞培養用の培地。一般に動物細胞を培養する場合には、培養液中に10~20%程度を添加する。低濃度の場合は2%程度。マウスやニワトリの筋芽細胞は、低血清培地条件下で培養することにより増殖を停止し、筋管細胞(筋繊維の前分化段階)へと速やかに分化をはじめる。
※4 ウシ胎児血清:分娩前の雌ウシの胎児の血液から採取され、細胞培養用のサプリメントとして最も広く使用されている血液の血漿分画。多くの培養条件において細胞増殖をサポートするために必要で、1000以上の成分が含まれている。
※5 メチル-β-シクロデキストリン:デンプン由来の環状オリゴ糖の一つ。100%天然素材であり、食品添加物としても用いられる。バケツ状の構造は、外側が親水性、内側が疎水性の物性を持つため水溶性であり、さらに内腔にはさまざまな分子を包み込むことができ、コレステロール除去剤として用いられる。
※6 骨格筋細胞:骨格筋に含まれる細胞の総称。分化度が低い順に、筋芽細胞、筋管細胞、筋繊維があり、このうち増殖性を示すのは筋芽細胞のみ。
※7 筋線維:筋芽細胞が筋管細胞へと分化した後、細胞融合を繰り返し、多核の細長い形となる。それが束状に組織化されたものを筋繊維と呼ぶ。この筋線維が数多く集まって骨格筋が構成される。
※8 初代培養:細胞を組織から採取し、増殖させる培養段階。本研究では、胚から細胞を採取して培養している。
※9 コレステロール:コレステロールは生体膜(細胞膜)の主たる構成成分の一つであり、タンパク質やリン脂質とともにすべての細胞膜に含まれており、膜の流動性を調節する重要な働きをする。
※10 アポトーシス:管理・調節された細胞の自殺、つまりプログラムされた細胞死。オタマジャクシからカエルに変態する際に尻尾がなくなったり、指が形成されるような発生過程において、数多く認められる。一方、血行不良や外傷など、細胞内外の環境が悪化することによって起こる細胞死のことはネクローシスと呼ばれ、区別される。
【関連リンク】
農学部 生物機能科学科 講師 岡村 大治(オカムラ ダイジ)
https://www.kindai.ac.jp/meikan/1359-okamura-daiji.html